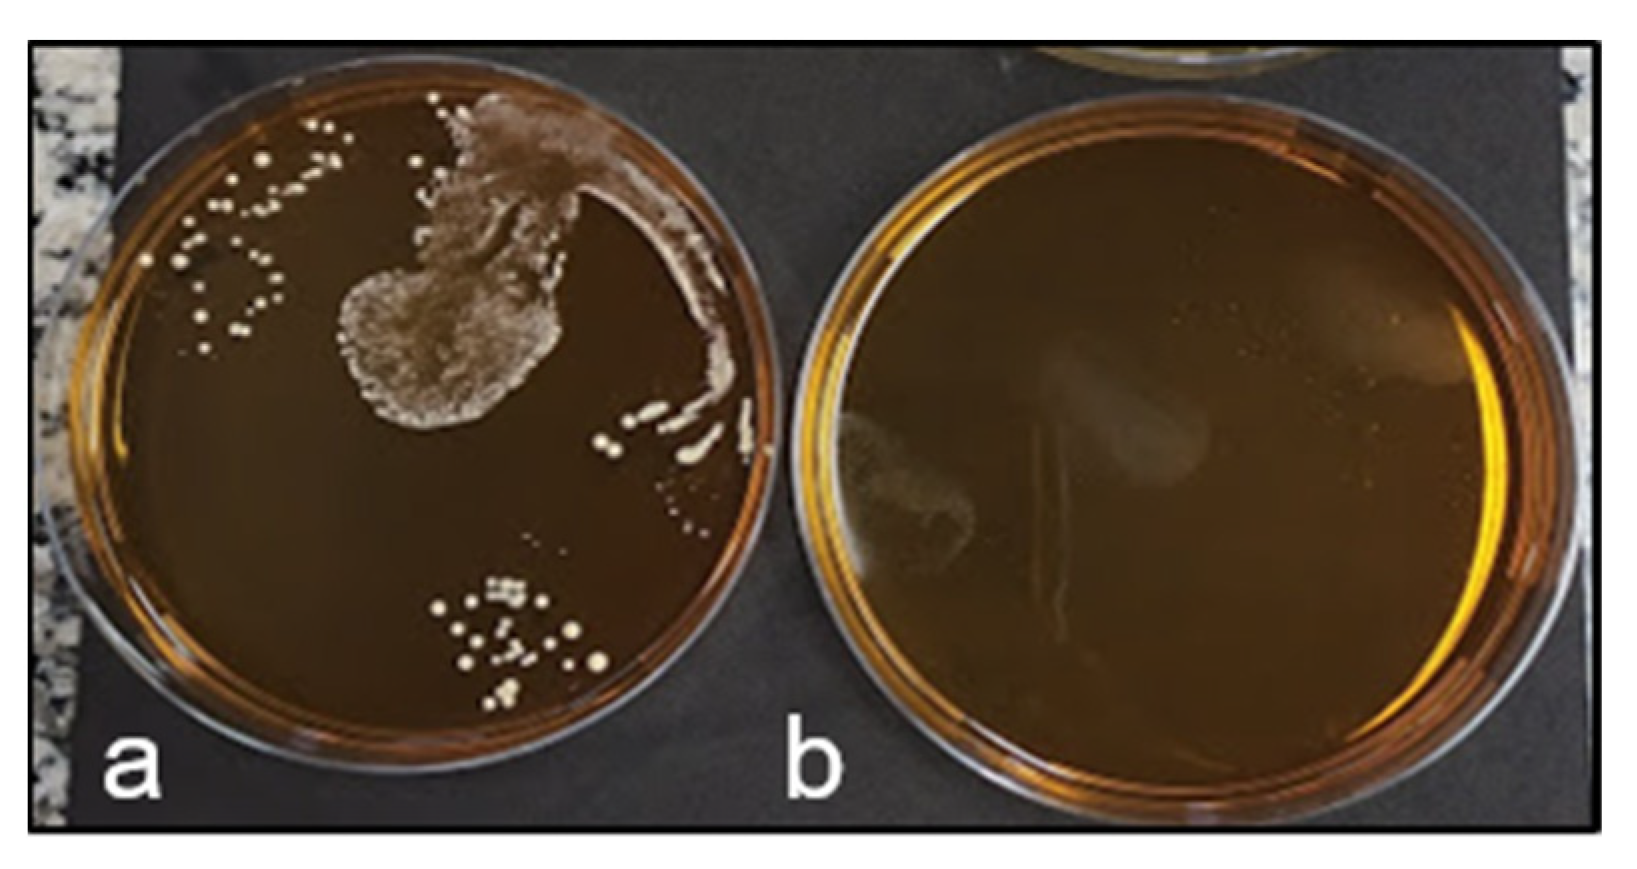
Fermentation 09 00089 g004 Fermentation 09 00089 g004

Integration of Corn and Cane for Ethanol Production: Effects of Lactobacilli Contamination on Fermentative Parameters and Use of Ionizing Radiation Treatment for Disinfection
Abstract
1. Introduction
- The composition of the energy cane juice would be a major factor affecting fermentative parameters (Study 1);
- The contamination with Lactobacillus spp. would increase the synthesis of secondary compounds, affecting the quality of the wort and reducing the fermentation efficiency (Study 2, part I);
- Ionizing radiation would be an effective technology to reduce/control the contaminants brought with the cane in the industrial process of corn ethanol production (Study 2, part II).
2. Materials and Methods
2.1. Study 1
2.1.1. Experimental Design
2.1.2. Analyses
2.2. Study 2
2.2.1. Wort Preparation
2.2.2. Contamination
2.2.3. Treatment with Ionizing Radiation
2.2.4. Fermentation: Experimental Design
2.2.5. Fermentation: Analyses
2.3. Statistical Analyses
3. Results and Discussion
3.1. Study 1
3.2. Study 2
3.2.1. Effects of Bacterial Contamination on Fermentative Parameters
3.2.2. Effects of Bacterial Contamination on Organic Acid Synthesis and pH
3.2.3. Disinfection with Ionizing Radiation
4. Conclusions
Supplementary Materials
Author Contributions
Funding
Data Availability Statement
Conflicts of Interest
References
- Ministry of Mines and Energy. Brazilian Energy Balance-Summary Report of 2020; Ministry of Mines and Energy: Brasília, Brazil, 2021.
- Grassi, M.C.B.; Pereira, G.A.G. Energy-Cane and RenovaBio: Brazilian Vectors to Boost the Development of Biofuels. Ind. Crop. Prod. 2019, 129, 201–205. [Google Scholar] [CrossRef]
- Ministry of Mines and Energy Brazilian Ten-Year Energy Expansion Plan. Available online: http://www.epe.gov.br/sites-pt/publicacoes-dados-abertos/publicacoes/Documents/PDE2027_aprovado_OFICIAL.pdf (accessed on 5 February 2020).
- RFA (Renewable Fuels Association) 2020 Ethanol Industry Outlook. Available online: www.eenergyadams.com (accessed on 7 February 2021).
- UNICA Production and Milling History-Total Ethanol Production, 2019/2020. Available online: https://observatoriodacana.com.br/historico-de-producao-e-moagem.php?idMn=31&tipoHistorico=2&acao=visualizar&idTabela=2448&produto=etanol_total&safraIni=2019%2F2020&safraFim=2019%2F2020&estado=SP&idioma=2 (accessed on 18 January 2021).
- Goldemberg, J. Ethanol for a Sustainable Energy Future. Sci. AAAS 2007, 315, 808–810. [Google Scholar] [CrossRef] [PubMed]
- Macedo, I.C.; Seabra, J.E.A.; Silva, J.E.A.R. Green House Gases Emissions in the Production and Use of Ethanol from Sugarcane in Brazil: The 2005/2006 Averages and a Prediction for 2020. Biomass Bioenergy 2008, 32, 582–595. [Google Scholar] [CrossRef]
- Hill, J. Environmental Costs and Benefits of Transportation Biofuel Production from Food- and Lignocellulose-Based Energy Crops. A Review. In Sustainable Agriculture; Lichtfouse, E., Navarrete, M., Debaeke, P., Véronique, S., Alberola, C., Eds.; Springer: Dordrecht, The Netherlands, 2009; Volume 27, pp. 125–139. [Google Scholar]
- FAO FAOSTAT. Available online: http://www.fao.org/faostat/en/#data/QC (accessed on 10 November 2019).
- Barros, S.; Woody, K. Corn Ethanol Production Booms in Brazil; United States Deparment of Agriculture (USDA): Brasilia, Brazil, 2020.
- CerradinhoBIO Cerradinho Bio Creates Business Division for Products Derived from Corn. Available online: https://www.cerradinhobio.com.br/en/news/cerradinho-bio-creates-business-division-for-products-derived-from-corn/ (accessed on 19 December 2022).
- Sica, P.; Prado, L.M.L.M.; Granja, P.; de Carvalho, E.M.; Mattos, E.d.C.; Calegari, R.P.; Silverio, M.; Martins, B.C.; Baptista, A.S. Effects of Energy Cane (Saccharum spp.) Juice on Corn Ethanol (Zea Mays) Fermentation Efficiency: Integration towards a More Sustainable Production. Fermentation 2021, 7, 30. [Google Scholar] [CrossRef]
- Sica, P. Sugarcane Breeding for Enhanced Fiber and Its Impacts on Industrial Processes. In Sugarcane-Biotechnology for Biofuels; Khan, M.S., Ed.; IntechOpen: London, UK, 2021; p. 16. [Google Scholar]
- Knoll, J.E.; Anderson, W.F.; Richard, E.P.; Doran-Peterson, J.; Baldwin, B.; Hale, A.L.; Viator, R.P. Harvest Date Effects on Biomass Quality and Ethanol Yield of New Energycane (Saccharum Hyb.) Genotypes in the Southeast USA. Biomass Bioenergy 2013, 56, 147–156. [Google Scholar] [CrossRef]
- Ceccato-Antonini, S.R.; Bassi, A.P.G.; Paraluppi, A.L.; dos Santos, E.G.D.; Matsuoka, S. Deterioration and Fermentability of Energy Cane Juice. Cienc. Rural. 2017, 47, e20160860. [Google Scholar] [CrossRef]
- Thomas, K.C.; Hynes, S.H.; Ingledew, W.M. Effect of Lactobacilli on Yeast Growth, Viability and Batch and Semi-Continuous Alcoholic Fermentation of Corn Mash. J. Appl. Microbiol. 2001, 90, 819–828. [Google Scholar] [CrossRef] [PubMed]
- Aquarone, E. Penicillin and Tetracycline as Contamination Control Agents in Alcoholic Fermentation of Sugar Cane Molasses. Appl. Microbiol. 1959, 8, 263–268. [Google Scholar] [CrossRef]
- Day, W.H.; Serjak, W.C.; Stratton, J.R.; Stone, L. Antibiotics as Contamination-Control Agents In Grain Alcohol Fermentations. J. Agric. Food Chem. 1954, 2, 252–258. [Google Scholar] [CrossRef]
- Hynes, S.H.; Kjarsgaard, D.M.; Thomas, K.C.; Ingledew, W.M. Use of Virginiamycin to Control the Growth of Lactic Acid Bacteria during Alcohol Fermentation. J. Ind. Microbiol. Biotechnol. 1997, 18, 284–291. [Google Scholar] [CrossRef] [PubMed]
- Islam, M.; Toledo, R.; Hamdy, M.K. Stability of Virginiamycin and Penicillin during Alcohol Fermentation. J. Biosci. Bioenergy 1999, 17, 369–376. [Google Scholar] [CrossRef]
- Frieri, M.; Kumar, K.; Boutin, A. Antibiotic Resistance. J. Infect. Public Health 2017, 10, 369–378. [Google Scholar] [CrossRef]
- Al-Assaf, S.; Coqueret, X.; Dahlan, K.Z.H.M.; Sen, M.; Ulanski, P. The Radiation Chemistry of Polysaccharides; International Atomic Energy Agency: Vienna, Austria, 2016; Volume 124, ISBN 978-92-0-101516-7.
- Molins, R.A. Food Irradiation: Principles and Applications, 1st ed.; John Wiley & Sons: Hoboken, NJ, USA, 2001; ISBN 0471356344. [Google Scholar]
- Bhat, R.; Karim Alias, A.; Paliyath, G. Use of Electron Beams in Food Preservation. In Progress in Food Preservation; Bhat, R., Abd Karim Alias, G.P., Eds.; Wiley-Blackwell: Oxford, UK, 2012; Volume 17, pp. 343–372. [Google Scholar]
- Borrely, S.I.; Del Mastro, N.L.; Sampa, M.H.O. Improvement of Municipal Wastewaters by Electron Beam Accelerator in Brazil. Radiat. Phys. Chem. 1998, 52, 333–337. [Google Scholar] [CrossRef]
- Podadera, P. Estudo Das Propriedades Do Açúcar Líquido Invertido Processado Com Radiação Gama e Feixe de Elétrons. Ph.D. Thesis, University of Sao Paulo, Sao Paulo, Brazil, 2007. [Google Scholar]
- Rela, P.R. Desenvolvimento De Dispositivo De Irradiação Para Tratamento De Efluentes Industriais Com Feixe De Elétrons. Ph.D. Thesis, University of Sao Paulo, Sao Paulo, Brazil, 2003. [Google Scholar]
- Calegari, R.P.; da Silva, E.A.; da Silva, A.P.M.; Gomes, M.P.; Mota, L.A.; Arthur, V.; Baptista, A.S. Wort Disinfection Treatment with Electron Beam for Bioethanol Production. Sci. Agric. 2023, 80. [Google Scholar] [CrossRef]
- Pierce, J.S. Institute of Brewing: Analysis Committee Measurement of Yeast Viability. J. Inst. Brew. 1970, 76, 442–443. [Google Scholar] [CrossRef]
- Oliveira, A.; Gallo, C.; Alcarde, V.; Godoy, A.; Amorim, H. Methods for Microbiological Control in Sugar and Alcohol Production, 1st ed.; FERMENTEC: Piracicaba, Brazil; ESALQ: Piracicaba, Brazil; FEALQ: Piracicaba, Brazil, 1996; p. 89. (In Portuguese) [Google Scholar]
- Firmino, F.C.; Porcellato, D.; Cox, M.; Suen, G.; Broadbent, J.R.; Steele, J.L. Characterization of Microbial Communities in Ethanol Biorefineries. J. Ind. Microbiol. Biotechnol. 2020, 47, 183–195. [Google Scholar] [CrossRef] [PubMed]
- Roy, D. Media for the Isolation and Enumeration of Bifidobacteria in Dairy Products. Int. J. Food Microbiol. 2001, 69, 167–182. [Google Scholar] [CrossRef] [PubMed]
- LarborClin MRS Agar Lactobacilus. Available online: https://www.laborclin.com.br/wp-content/uploads/2019/06/MRS_Agar_Lactobacilus.pdf (accessed on 14 December 2022).
- Prado, R.D.M.; Caione, G.; Campos, C.N.S. Filter Cake and Vinasse as Fertilizers Contributing to Conservation Agriculture. Appl. Environ. Soil Sci. 2013, 2013, 581984. [Google Scholar] [CrossRef]
- Silva, N.D.; Alvim, M.R.; Rosario, C.G.A.; Espinosa, D.C.R.; Baltazar, M. dos P.G. Nutrients’ Supplementation Impacts on Alcholoic Fermentation of Corn and Sugarcane Mixed Wort. Res. Sq. Prepriting 2022, 1, 1–26. [Google Scholar] [CrossRef]
- Knoll, J.E.; Anderson, W.F.; Missaoui, A.; Hale, A.; Hanna, W.W. Biomass Production and Stability of Five Energycane Cultivars at Two Latitudes in Georgia. Agrosystems Geosci. Environ. 2021, 4, 1–14. [Google Scholar] [CrossRef]
- Alterthum, F.; Cruz, M.R.M.; Vairo, M.L.R.; Gambassi, D.M. Effect of Contaminating Microorganisms of Alcoholic Fermentation on Microdistilleries (in Portuguese). STAB. Açúcar, Álcool Subprodutos 1984, 3, 42–49. [Google Scholar]
- Graves, T.; Narendranath, N.V.; Dawson, K.; Power, R. Effect of PH and Lactic or Acetic Acid on Ethanol Productivity by Saccharomyces Cerevisiae in Corn Mash. J. Ind. Microbiol. Biotechnol. 2006, 33, 469–474. [Google Scholar] [CrossRef] [PubMed]
- Graves, T.; Narendranath, N.V.; Dawson, K.; Power, R. Interaction Effects of Lactic Acid and Acetic Acid at Different Temperatures on Ethanol Production by Saccharomyces Cerevisiae in Corn Mash. Appl. Microbiol. Biotechnol. 2007, 73, 1190–1196. [Google Scholar] [CrossRef] [PubMed]
- Thomas, K.C.; Hynes, S.H.; Ingledew, W.M. Influence of Medium Buffering Capacity on Inhibition of Saccharomyces Cerevisiae Growth by Acetic and Lactic Acids. Appl. Environ. Microbiol. 2002, 68, 1616–1623. [Google Scholar] [CrossRef] [PubMed]
- Giannattasio, S.; Guaragnella, N.; Ždralević, M.; Marra, E. Molecular Mechanisms of Saccharomyces Cerevisiae Stress Adaptation and Programmed Cell Death in Response to Acetic Acid. Front. Microbiol. 2013, 4, 1–7. [Google Scholar] [CrossRef]
- Burtner, C.R.; Murakami, C.J.; Kennedy, B.K.; Kaeberlein, M. A Molecular Mechanism of Chronological Aging in Yeast. Cell Cycle 2009, 8, 1256–1270. [Google Scholar] [CrossRef]
- Ludovico, P.; Sousa, M.J.; Silva, M.T.; Leão, C.; Côrte-Real, M. Saccharomyces Cerevisiae Commits to a Programmed Cell Death Process in Response to Acetic Acid. Microbiology 2001, 147, 2409–2415. [Google Scholar] [CrossRef]
- Boraam, F.; Faid, M.; Larpent, J.P.; Breton, A. Lactic Acid Bacteria and Yeast Associated with Traditional Moroccan Sour-Dough Bread Fermentation. Sci. Aliment. 1993, 13, 501–509. [Google Scholar]
- Walksman, S.A. Microbial Antagonism and Antibiotic Subastances. Oxford Univ. Press 1945, 129, 531–533. [Google Scholar]
- Narendranath, N.V.; Hynes, S.H.; Thomas, K.C.; Ingledew, W.M. Effects of Lactobacilli on Yeast-Catalyzed Ethanol Fermentations. Appl. Environ. Microbiol. 1997, 63, 4158–4163. [Google Scholar] [CrossRef]
- Maiorella, B.L.; Blanch, H.W.; Wilke, C.R. Economic Evaluation of Alternative Ethanol Fermentation Processes. Biotechnol. Bioeng. 1984, 26, 1003–1025. [Google Scholar] [CrossRef] [PubMed]
- Ngang, J.J.E.; Letourneau, F.; Wolniewicz, E.; Villa, P. Applied Microbiology Biotechnology Inhibition of Beet Molasses Alcoholic Fermentation by Lactobacilli. Appl. Microbiol. Biotechnol. 1990, 33, 490–493. [Google Scholar]
- Cherubin, R.A. Efeitos Da Viabilidade Da Levedura e Da Contaminação Bacteriana Na Fermentação Alcoólica. Ph.D. Thesis, University of Sao Paulo, Sao Paulo, Brazil, 2003. [Google Scholar]
- Heerde, E.; Radler, F. Metabolism of the Anaerobic Formation of Succinic Acid by Saccharomyces Cerevisiae. Arch. Microbiol. 1978, 117, 269–276. [Google Scholar] [CrossRef]
- Basso, L.C.; Alves, D.M.G.; Amorim, H.V. The Antibacterial Action of Succinic Acid Formation by Yeast during Fermentation. Rev. Microbiol. 1997, 28, 77–82. [Google Scholar]
- Bayrock, D.P.; Ingledew, W.M. Inhibition of Yeast by Lactic Acid Bacteria in Continuous Culture: Nutrient Depletion and/or Acid Toxicity? J. Ind. Microbiol. Biotechnol. 2004, 31, 362–368. [Google Scholar] [CrossRef] [PubMed]
- Bayrock, D.P.; Michael Ingledew, W. Application of Multistage Continuous Fermentation for Production of Fuel Alcohol by Very-High-Gravity Fermentation Technology. J. Ind. Microbiol. Biotechnol. 2001, 27, 87–93. [Google Scholar] [CrossRef]
- Song, H.; Lee, S.Y. Production of Succinic Acid by Bacterial Fermentation. Enzyme Microb. Technol. 2006, 39, 352–361. [Google Scholar] [CrossRef]
- Bertolini, L.; Zambonelli, C.; Giudici, P.; Castellari, L. Higher Alcohol Production by Cryotolerant Saccharomyces Strains. Am. J. Enol. Vitic. J. Enol. Vitic. 1996, 47, 343–345. [Google Scholar]
- Casey, E.; Sedlak, M.; Ho, N.W.Y.; Mosier, N.S. Effect of Acetic Acid and PH on the Cofermentation of Glucose and Xylose to Ethanol by a Genetically Engineered Strain of Saccharomyces Cerevisiae. FEMS Yeast Res. 2010, 10, 385–393. [Google Scholar] [CrossRef]
- Jönsson, L.J.; Alriksson, B.; Nilvebrant, N.-O. New Developments in Microwave Histoprocessing. Am. Biotechnol. Lab. 2003, 21, 40. [Google Scholar]
- Jönsson, L.J.; Martín, C. Pretreatment of Lignocellulose: Formation of Inhibitory by-Products and Strategies for Minimizing Their Effects. Bioresour. Technol. 2016, 199, 103–112. [Google Scholar] [CrossRef] [PubMed]
- Palmqvist, E.; Hahn-Hägerdal, B. Fermentation of Lignocellulosic Hydrolysates. II: Inhibitors and Mechanisms of Inhibition. Bioresour. Technol. 2000, 74, 25–33. [Google Scholar] [CrossRef]
- Geng, P.; Zhang, L.; Shi, G.Y. Omics Analysis of Acetic Acid Tolerance in Saccharomyces Cerevisiae. World J. Microbiol. Biotechnol. 2017, 33, 1–8. [Google Scholar] [CrossRef] [PubMed]
- Bellissimi, E.; Van Dijken, J.P.; Pronk, J.T.; Van Maris, A.J.A. Effects of Acetic Acid on the Kinetics of Xylose Fermentation by an Engineered, Xylose-Isomerase-Based Saccharomyces Cerevisiae Strain. FEMS Yeast Res. 2009, 9, 358–364. [Google Scholar] [CrossRef] [PubMed]
- Swinnen, S.; Fernández-Niño, M.; González-Ramos, D.; van Maris, A.J.A.; Nevoigt, E. The Fraction of Cells That Resume Growth after Acetic Acid Addition Is a Strain-Dependent Parameter of Acetic Acid Tolerance in Saccharomyces Cerevisiae. FEMS Yeast Res. 2014, 14, 642–653. [Google Scholar] [CrossRef]
- HENTGES, D.J. Influence of PH on the Inhibitory Activity of Formic and Acetic Acids for Shigella. J. Bacteriol. 1967, 93, 2029–2030. [Google Scholar] [CrossRef]
- Maia, N.J.L.; Corrêa, J.A.F.; Rigotti, R.T.; da Silva Junior, A.A.; Luciano, F.B. Combination of Natural Antimicrobials for Contamination Control in Ethanol Production. World J. Microbiol. Biotechnol. 2019, 35, 158. [Google Scholar] [CrossRef]
- Hoff, R.B.; Molognoni, L.; Deolindo, C.T.P.; de Oliveira, T.; Mattos, J.L.S.; de Oliveira, L.V.A.; Daguer, H.; Mattos, J.L.S. Residues of Antibiotics in Yeasts from Ethanol Production: A Possible Contamination Route for Feedingstuffs. J. Environ. Sci. Health Part B 2021, 56, 307–312. [Google Scholar] [CrossRef]
- World Bank. Drug-Resistant Infections: A Threat to Our Economic Future; World Bank: Washington, DC, USA, 2017. [Google Scholar]

| Sucrose | Fructose | Glucose | Mannitol | Glycerol | |
|---|---|---|---|---|---|
| g L−1 | |||||
| Energy cane | 98.2 | 26.6 | 28.4 | 7.89 | 2.32 |
| Study 1 | |||
|---|---|---|---|
| Corn | Mixture | ||
| Ethanolcontent | % | 10.6 ± 0.7 | 10.3 ± 0.2 |
| Cell viability | 90.2 ± 1.9 | 93.5 ± 1.1 | |
| Glycerol | g L−1 | 1.49 ± 0.2 | 1.54 ± 0.07 |
| Acetic acid | 0.47 ± 0.02 | 0.48 ± 0.01 | |
| Residual sugars | |||
| Sucrose | mg L−1 | n.d. | n.d. |
| Glucose | n.d. | n.d. | |
| Fructose * | 634 ± 62 a | 382 ± 58 b | |
Disclaimer/Publisher’s Note: The statements, opinions and data contained in all publications are solely those of the individual author(s) and contributor(s) and not of MDPI and/or the editor(s). MDPI and/or the editor(s) disclaim responsibility for any injury to people or property resulting from any ideas, methods, instructions or products referred to in the content. |
© 2023 by the authors. Licensee MDPI, Basel, Switzerland. This article is an open access article distributed under the terms and conditions of the Creative Commons Attribution (CC BY) license (https://creativecommons.org/licenses/by/4.0/).
Share and Cite
Silva, A.P.M.d.; Sica, P.; Pires, L.d.A.N.; Spironello, L.; Mota, L.A.; Peixoto, G.T.; Calegari, R.P.; Basso, T.O.; Tonso, A.; Gomes, M.P.; et al. Integration of Corn and Cane for Ethanol Production: Effects of Lactobacilli Contamination on Fermentative Parameters and Use of Ionizing Radiation Treatment for Disinfection. Fermentation 2023, 9, 89. https://doi.org/10.3390/fermentation9020089
Silva APMd, Sica P, Pires LdAN, Spironello L, Mota LA, Peixoto GT, Calegari RP, Basso TO, Tonso A, Gomes MP, et al. Integration of Corn and Cane for Ethanol Production: Effects of Lactobacilli Contamination on Fermentative Parameters and Use of Ionizing Radiation Treatment for Disinfection. Fermentation. 2023; 9(2):89. https://doi.org/10.3390/fermentation9020089
Chicago/Turabian StyleSilva, Ana Paula Maria da, Pietro Sica, Lucas de Almeida Nobre Pires, Liandra Spironello, Layna Amorim Mota, Gustavo Theodoro Peixoto, Rubens Perez Calegari, Thiago Olitta Basso, Aldo Tonso, Marcelo Pego Gomes, and et al. 2023. "Integration of Corn and Cane for Ethanol Production: Effects of Lactobacilli Contamination on Fermentative Parameters and Use of Ionizing Radiation Treatment for Disinfection" Fermentation 9, no. 2: 89. https://doi.org/10.3390/fermentation9020089
APA StyleSilva, A. P. M. d., Sica, P., Pires, L. d. A. N., Spironello, L., Mota, L. A., Peixoto, G. T., Calegari, R. P., Basso, T. O., Tonso, A., Gomes, M. P., Somessari, S. L., Duarte, H. G., Somessari, E. S. R., Carvalho, R. d. S., & Baptista, A. S. (2023). Integration of Corn and Cane for Ethanol Production: Effects of Lactobacilli Contamination on Fermentative Parameters and Use of Ionizing Radiation Treatment for Disinfection. Fermentation, 9(2), 89. https://doi.org/10.3390/fermentation9020089

